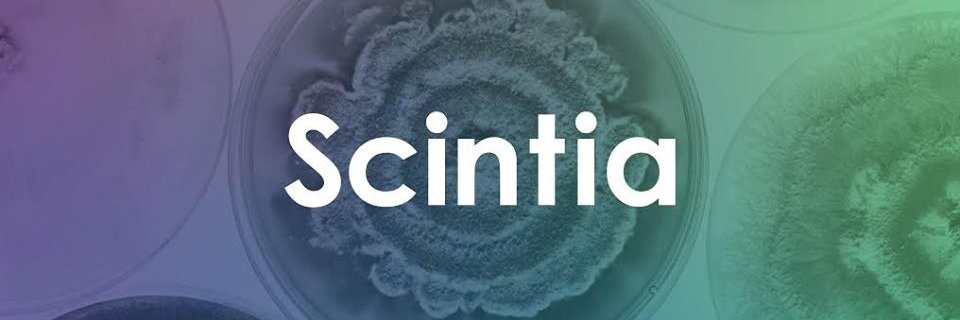
Scintia Bio banner

Scintia Bio
149 posts

Scintia Bio
@Scintia_mx
Facilitamos la manera de enseñar, investigar y emprender en biología sintética. #biotecnologia #synbio #stem #syntheticbiology #startup #diybio













Hoy estaré en vivo para hablar del taller de Biodiseño y Biología Sintética que tenemos con @cunamex No se lo pierdan @Scintia_mx












Ya vieron quiénes salen aquí? Este viernes en @SharkTankMex nuestros fundadores estarán frente a los Sharks. No te pierdas esta aventura y acompáñanos para ver a @Scintia_mx llevar el poder de la biotecnología a los tiburones. Este viernes 10PM por @SonyChannelLA #SharkTankMx

Minerva y Ricardo nos enamoraron porque su propuesta de valor transforma algo fundamental hoy: sube la vara en la educación científica y eso es de suma importancia a la hora de entrar a un mundo donde muchos trabajos serán reemplazados por máquinas. El ser humano no tiene otra



Hoy vi al equipo de @Scintia_mx en @SharkTankMex. Espero que a estas alturas de la pandemia los tiburones ya sepan qué es una #PCR y para qué sirve. #SinBiotecnologíaNoHayFuturo #SharkTankMx





